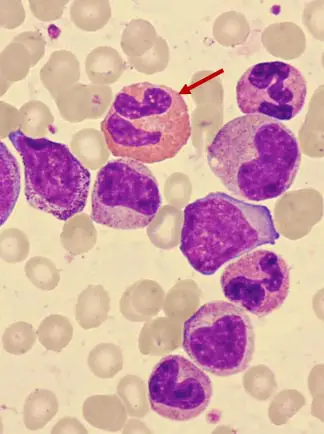
圖片描述

113年:(醫檢)血液(2)
圖中箭號標示的細胞為何?
AMyelocyte
BMetamyelocyte
CNeutrophil
DEosinophil
詳細解析
本題觀念:
辨識各階段粒細胞及嗜酸性球在血液塗片上的典型形態特徵,尤其是嗜酸性球(eosinophil)的特殊顆粒與核型。
影像分析:
從圖中可見:
- 紅箭頭標示之細胞體積略大於周圍紅血球,約12–15 µm。
- 細胞質充滿大量粗大、橘紅(紅-橘色)顆粒,與嗜酸性球的特異性顆粒相符。
- 核呈典型雙葉(bilobed),兩葉間以細絲狀染色質相連,染色質緊密濃縮。
- 顆粒大小均一、邊緣清晰,不會遮蔽核膜。
以上特徵符合成熟嗜酸性球(mature eosinophil)之經典形態。
選項分析
-
選項A Myelocyte
• Myelocyte 為較早期的顆粒球前驅,核呈圓形或輕度橢圓,核染色質較疏鬆,無分葉現象。
• 細胞質中可見原始(primary)顆粒和極少量次級顆粒,但顏色不會呈鮮明橘紅。
→ 與圖中雙葉核、橘紅顆粒不符,排除。 -
選項B Metamyelocyte
• Metamyelocyte 特徵為核高度凹陷(kidney-shaped),尚未分裂成雙或多葉;核未形成獨立葉片,呈腎形。
• 細胞質顆粒偏向中性或初級顆粒,顏色不鮮紅。
→ 淺紅或紫褐顆粒,且核型不同,故排除。 -
選項C Neutrophil
• 成熟中性球 (segmented neutrophi
...(解析預覽)...

升級 VIP 解鎖圖文解析